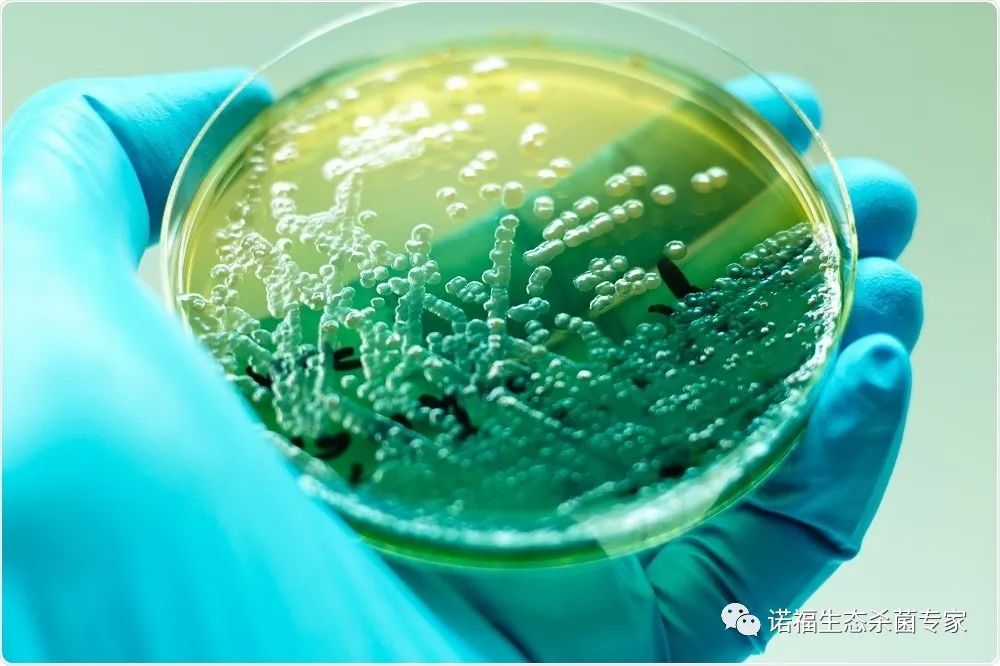

铜绿假单胞菌是一种广泛存在于自然界中的革兰氏阴性细菌,桶装水中,铜绿假单胞菌的存在可能源于原水、设备、管道、操作人员等方面,近年来包装饮用水中铜绿假单胞菌污染问题越来越严重。
近期笔者就收到了不少关于铜绿假单胞菌超标的咨询电话,除了桶装水和矿泉水厂家,还有苏打水和饮料厂家,这类客户主要是原水中含有铜绿假单胞菌。
铜绿假单胞菌污染可能导致以下问题:
1.对健康的影响:铜绿假单胞菌可可能引起人感觉不适。
2.水质变质:铜绿假单胞菌的存在可能导致桶装水的气味,味道和颜色发生变化,降低桶装水的品质和卫生指标,从而影响企业的形象和市场竞争力。
抛开铜绿假单胞菌超标有可能带来的问题,国家对饮用水铜绿假单胞菌检验标准也是不能忽视的。

铜绿假单胞菌的检验标准及限量要求
我国现行检验标准为GB 8538-2016《食品安全国家标准 饮用天然矿泉水检验方法》中“57 铜绿假单胞菌”。我国现行食品安全国家标准对铜绿假单胞菌的限量控制主要是针对包装饮用水和饮用天然矿泉水:GB 19298-2014《食品安全国家标准 包装饮用水》和GB 8537-2018《食品安全国家标准 饮用天然矿泉水》对铜绿假单胞菌的限量规定均为n=5,c=0,m=0(CFU/250ml)。
香港《食品微生物含量指引》规定瓶装/包装饮用水(天然矿泉水除外)中铜绿假单胞菌的限量为0/250ml;天然矿泉水中铜绿假单胞菌的限量为n=5,c=0,m=0(CFU/250ml)。
国际上也制定有相应的质量标准和生产操作规范,并对铜绿假单胞菌进行限量规定。如国际食品法典委员会发布的CAC/RCP 33-2011《采集、加工和销售天然矿泉水卫生规范守则》的规定为n=5,c=0,m=0(CFU/250ml);
欧盟98/83/EC《饮用水水质指令》对瓶装或容器中出售的水中铜绿假单胞菌限量要求为0/250ml,2009/54/EC《天然矿泉水的开采和销售指令》对生产和销售过程中天然矿泉水中铜绿假单胞菌限量要求为0/250mL。
以下是一些常见的包装饮用水车间规范操作流程:
1.原水预处理:使用专业的原水处理设备,如滤器,反渗透等,对原水进行预处理,去除其中的杂质和微生物。
2.设备清洗消毒;定期对桶装水生产设备进行清洗和消毒,消除铜绿假单胞菌等细菌的存在,消毒剂的浓度和作用时间需要严格控制,确保其达到消毒的效果,但不影响产品的品质和安全。
3.管道维护清洗:对管道进行定期维护清洗,消除管道内的污物和细菌。在生产过程中要注意避免管道内停留时间过长,以免细菌滋生。
4.操作员要求:对生产操作人员进行培训,加强其对卫生和无菌操作的认识,建立健全的操作规范和制度。操作人员在工作前应进行手部清洁和消毒,并佩戴相应的工作服、手套、口罩等防护用品。
5.定期监测:对生产环境、设备和产品进行定期监测,检测其是否存在铜绿假单胞菌等细菌的污染。监测频率和检测指标需要根据实际情况进行制定,并建立监测档案和记录。
6.不良品控制:在生产过程中,如发现桶装水存在异常气味,味道和颜色等不良品质,找出污染源并进行整改。

避免铜绿假单胞菌污染是桶装水生产企业必须重视的问题,需要采取科学的管理方法和规范操作流程,从而确保桶装水的质量和安全。常用的消毒方法是预防铜绿假单胞菌超标的关键的方法,选择好用的消毒剂又是消毒的关键。
对于铜绿假单胞菌的去除,润联是很有话语权的,在处理铜绿这块润联有绝对专业且治理经验丰富的技术人员,以及比利时进口的环保型诺福过氧化氢银离子杀菌剂,可高效杀灭铜绿假单胞菌,特点是作用快而强,能杀死所有微生物,应用广泛。

作为新一代的生态环保型杀菌、消毒剂,诺福以其独有的生产技术,基于“活性胶质银离子”以及“食品级过氧化氢”,成为领先全球的产品,深受各行各业企业的喜爱。
“活性胶质银离子”以及“食品级过氧化氢”,这两种成份作用的机理是:能穿透和破坏微生物的细胞壁和细胞膜,进入细胞内部使其关键性功能成分(例如:DNA和酶)坏死,从而导致细胞死亡,这种独特的机理也保证了病原菌不会产生耐药性,所以,润联所提供的解决方案可以有效解决铜绿假单胞菌耐药性难题。

专业处理桶装水铜绿假单胞菌超标、饮用水铜绿假单胞菌超标、苏打水原水铜绿假单胞菌超标、饮料原水铜绿假单胞菌超标,提供专业技术一对一解疑,详询润联张工18938962967微信同号。

推荐阅读⬇️